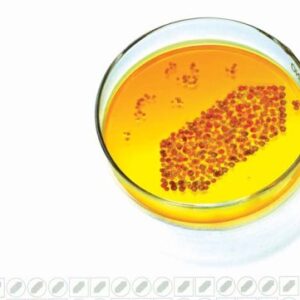
One Show Rx 2004

ANNA SWEWLLS
Showing 805–816 of 1555 resultsSorted by latest
-
Other Books
Visual Merchandising 2
Original price was: ₹2,702.00.₹2,027.00Current price is: ₹2,027.00. Pre-Order -
Other Books
One Show Rx 2004
Original price was: ₹1,540.00.₹1,155.00Current price is: ₹1,155.00. Pre-Order -
Other Books
Famous Addresses
Original price was: ₹2,500.00.₹1,875.00Current price is: ₹1,875.00. Pre-Order -
Other Books
The Copy Book
Original price was: ₹1,621.00.₹1,216.00Current price is: ₹1,216.00. Pre-Order -
Other Books
Prints Regional Design Annual 2005
Original price was: ₹3,474.00.₹2,606.00Current price is: ₹2,606.00. Pre-Order -
Other Books
Prints Best Letterheads & Business Cards
Original price was: ₹2,698.00.₹2,024.00Current price is: ₹2,024.00. Pre-Order -
Other Books
Graphic Design That Works
Original price was: ₹1,930.00.₹1,448.00Current price is: ₹1,448.00. Pre-Order -
Other Books
Famous Animal Symbols
Original price was: ₹3,237.00.₹2,428.00Current price is: ₹2,428.00. Pre-Order -
Other Books
The Positive Side
Original price was: ₹1,295.00.₹971.00Current price is: ₹971.00. Pre-Order -
Other Books
Classic Mehendi Designs
Original price was: ₹30.00.₹23.00Current price is: ₹23.00. Pre-Order -
Other Books
The Complete Photo Guide To Outdoor Home Improve Ment
Original price was: ₹1,617.00.₹1,213.00Current price is: ₹1,213.00. Pre-Order